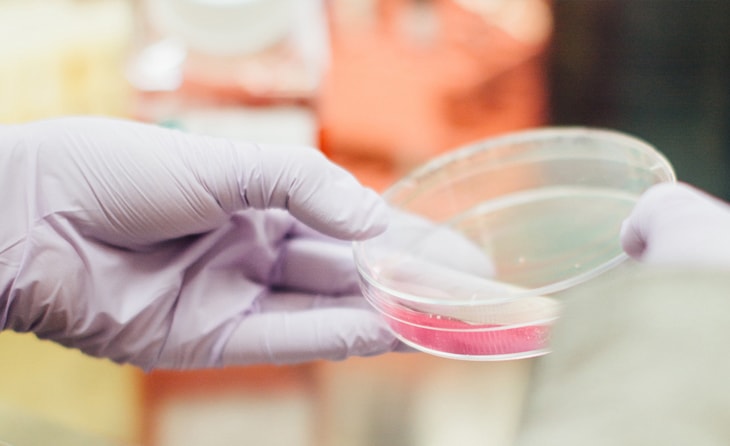

Lorem ipsum dolor sit amet, consectetur adipiscing elit. Duis nec facilisis nullano volutpat justo. Nulla tempus ultricies feugiat. Duis magna risus, luctus id urna dapibus condimentum dui. Maecenas tempor non…
Top 10 Misleading Marketing Tactics
Lorem ipsum dolor sit amet, consectetur adipiscing elit. Duis nec facilisis nullano volutpat justo. Nulla tempus ultricies feugiat. Duis magna risus, luctus id urna dapibus condimentum dui. Maecenas tempor non…
Best Practices for Raising Capital for Your Startup
Lorem ipsum dolor sit amet, consectetur adipiscing elit. Duis nec facilisis nullano volutpat justo. Nulla tempus ultricies feugiat. Duis magna risus, luctus id urna dapibus condimentum dui. Maecenas tempor non…